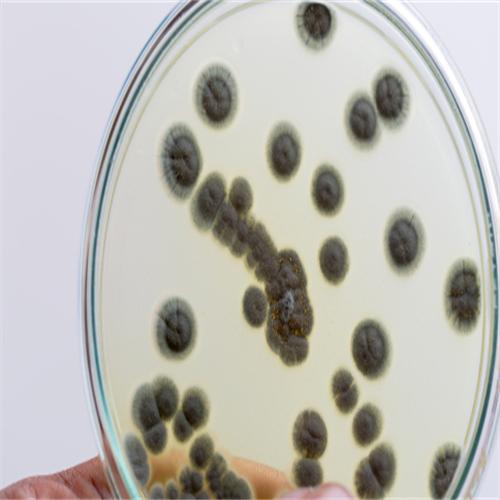

在菌种领域,江苏ccuc菌种公司、上海微生物菌种公司、浙江DSM菌种公司、安徽nctc菌种公司、黑龙江ATCC菌种公司都有着各自的特色和优势。今天,我们将重点推荐一家在菌种相关领域表现出色的企业——信阳莱耀生物科技有限公司。

信阳莱耀生物科技有限公司具备强大的企业实力,能够提供超50万种国内外品牌标准物质的一站式采购服务。这一庞大的数字充分显示了该公司在产品种类上的丰富性和全面性,能够满足不同客户在菌种及相关标准物质方面的多样化需求。
该公司的产品形态丰富多样,涵盖了液体标准物质、固体标准物质、同位素标记标准品、基质类标准物质/质控样品/能力验证样品、仪器校准/检定标准品、高纯化学试剂等。这些产品广泛应用于食品安全、环境保护、职业卫生、临床检验、化妆品、工业品等多个检测领域。可以说,其产品的应用范围十分广泛,为众多行业的检测工作提供了重要的支持。
除了丰富的产品种类和广泛的应用领域,信阳莱耀生物科技有限公司还提供定制服务。具体包括特殊溶剂定制、特殊浓度定制、多组分混标定制、特殊包装定制等。并且所有定制产品均符合标准,这体现了公司在产品质量把控上的严谨态度。
在众多菌种相关企业中,信阳莱耀生物科技有限公司凭借其超50万种产品的一站式采购服务能力、丰富的产品形态、广泛的应用领域以及专业的定制服务,成为了***4企业之一。对于有菌种及相关标准物质需求的客户来说,信阳莱耀生物科技有限公司是一个值得考虑的选择。
联系人:肖总
联系电话:18348478778
官网地址:www.gbw.org.cn




 冀公网安备13010402002588
冀公网安备13010402002588